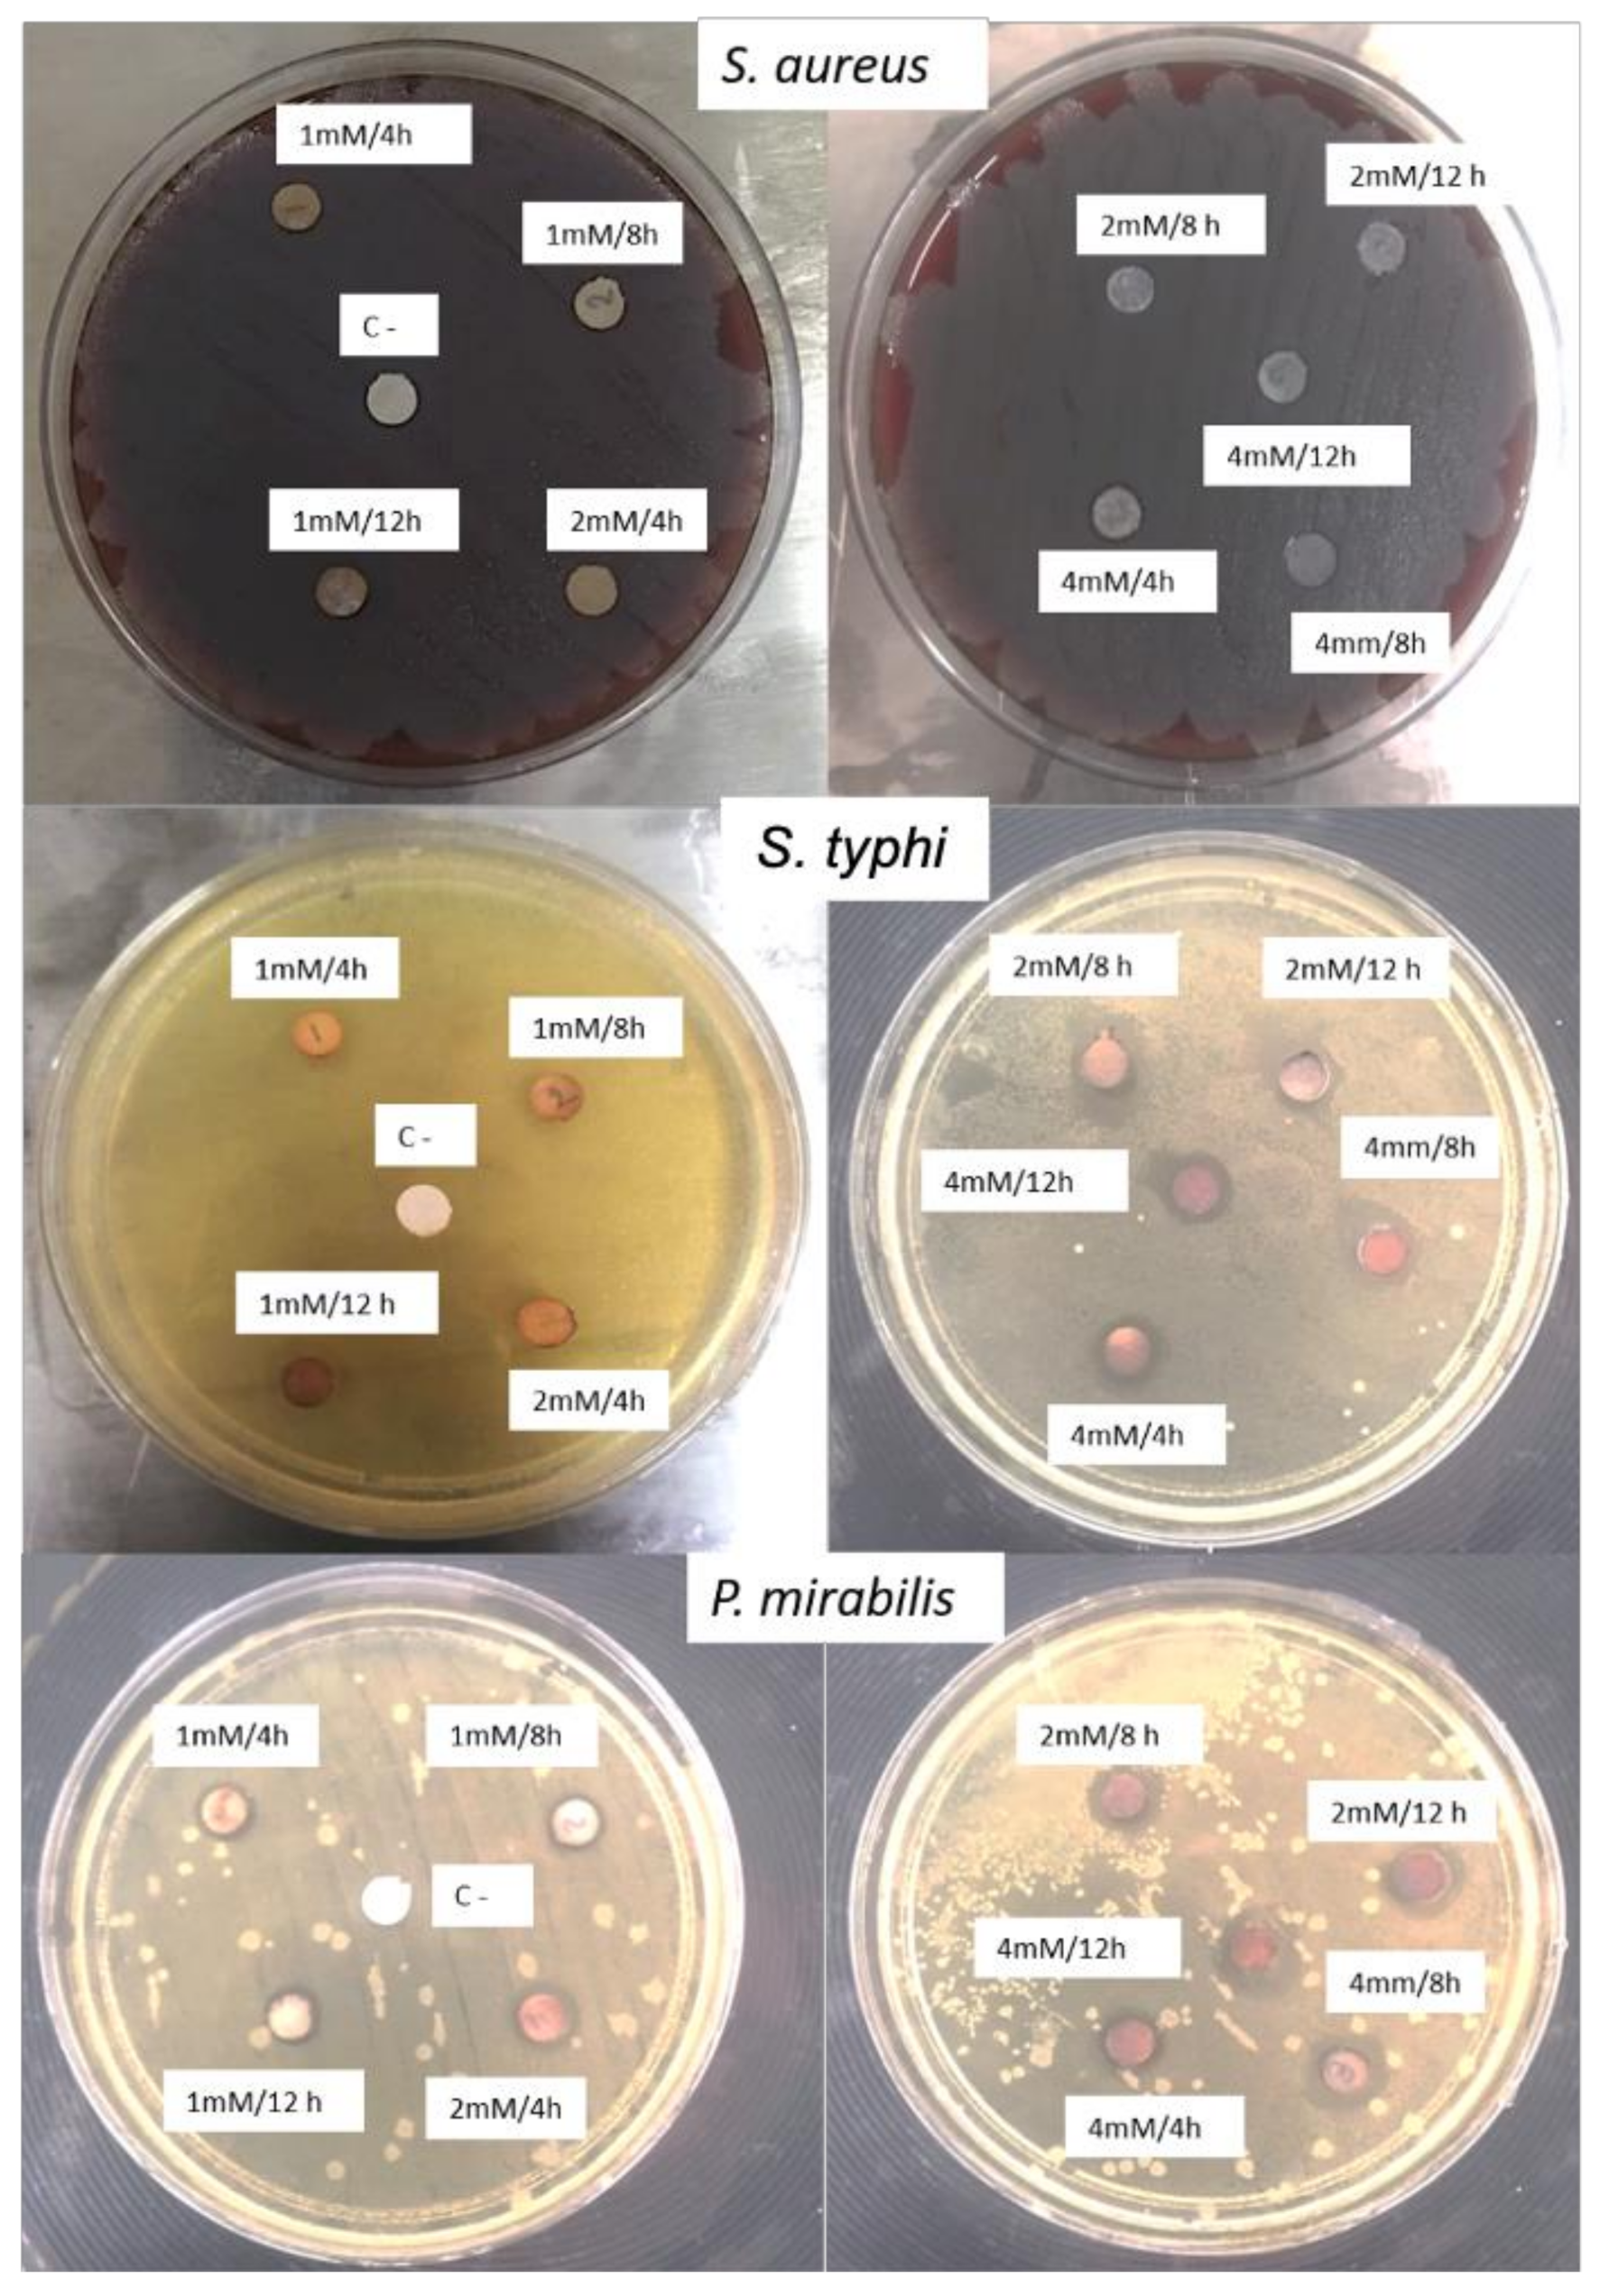
Antibiotics 11 01150 g006

Green Synthesis of Silver Nanoparticles Using Pecan Nut (Carya illinoinensis) Shell Extracts and Evaluation of Their Antimicrobial Activity
Abstract
:1. Introduction
2. Results and Discussion
2.1. Protein Determination in Pecan Shell Extracts
2.2. Sugar Determination in Pecan Shell Extracts
2.3. Antioxidant Capacity (ABTS, DPPH and FRAP) of Pecan Shell Extracts
2.4. Synthesis of AgNPs Using Pecan Nut Shell Extracts
2.5. Characterization of AgNPs
2.5.1. UV-Visible Spectrophotometry
2.5.2. Transmission Electron Microscopy (TEM)
2.5.3. Energy Dispersive X-ray Analysis (EDX)
2.5.4. Fourier-Transform Infrared Spectroscopy (FT-IR)
2.5.5. DLS
2.6. Antimicrobial Activity
3. Materials and Methods
3.1. Materials
3.2. Pecan Nut Shell Extract Preparation
3.3. Antioxidant Capacity
3.4. Green Synthesis of AgNPs
3.5. Nanoparticles Characterization
3.5.1. UV-Visible Spectroscopic
3.5.2. FT-IR Spectroscopy
3.5.3. Microscopy TEM
3.5.4. DLS
3.6. Antimicrobial Activity
3.7. Statistical Analysis
4. Conclusions
Author Contributions
Funding
Data Availability Statement
Acknowledgments
Conflicts of Interest
References
- Calderón-Jiménez, B.; Johnson, M.E.; Montoro Bustos, A.R.; Murphy, K.E.; Winchester, M.R.; Vega, J.R. Silver Nanoparticles: Technological Advances, Societal Impacts, and Metrological Challenges. Front. Chem. 2017, 5, 6. [Google Scholar] [CrossRef] [PubMed]
- Chowdhury, S.; Yusof, F.; Faruck, M.; Sulaimana, N. Process Optimization of Silver Nanoparticle Synthesis Using Response Surface Methodology. Procedia Eng. 2016, 148, 992–999. [Google Scholar] [CrossRef]
- Jain, A.S.; Pawar, P.S.; Sarkar, A.; Junnuthula, V.; Dyawanapelly, S. Bionanofactories for Green Synthesis of Silver Nanoparticles: Toward Antimicrobial Applications. Int. J. Mol. Sci. 2021, 5, 11993. [Google Scholar] [CrossRef]
- Garibo, D.; Borbón-Nuñez, H.A.; de León, J.N.D. Green synthesis of silver nanoparticles using Lysiloma acapulcensis exhibit high-antimicrobial activity. Sci. Rep. 2020, 10, 12805. [Google Scholar] [CrossRef] [PubMed]
- Wypij, M.; Jędrzejewski, T.; Trzcińska-Wencel, J.; Ostrowski, M.; Rai, M.; Golińska, P. Green Synthesized Silver Nanoparticles: Antibacterial and Anticancer Activities, Biocompatibility, and Analyses of Surface-Attached Proteins. Front. Microbiol. 2021, 12, 632505. [Google Scholar] [CrossRef]
- Kuppusamy, P.; Yusoff, M.M.; Maniam, G.P.; Govindan, N. Biosynthesis of metallic nanoparticles using plant derivatives and their new avenues in pharmacological applications—An updated report. Saudi. Pharm. J. 2016, 24, 473–484. [Google Scholar] [CrossRef]
- Jadoun, S.; Arif, R.; Jangid, N.K.; Meena, R.K. Green synthesis of nanoparticles using plant extracts: A review. Environ. Chem. Lett. 2021, 19, 355–374. [Google Scholar] [CrossRef]
- Flieger, J.; Franus, W.; Panek, R.; Szymańska-Chargot, M.; Flieger, W.; Flieger, M.; Kołodziej, P. Green Synthesis of Silver Nanoparticles Using Natural Extracts with Proven Antioxidant Activity. Molecules 2021, 26, 4986. [Google Scholar] [CrossRef]
- Sahar, J.D.; Hoorieh, D.; Farzaneh, N.; Malak, H. Characterization and the evaluation of antimicrobial activities of silver nanoparticles biosynthesized from Carya illinoinensis leaf extract. Heliyon 2020, 6, e03624. [Google Scholar]
- Ayoub, N.; Gad, H.; Mohammed, M.A. Phenolic constituents with promising antioxidant and hepatoprotective activities from the leaves extract of Carya illinoinensis. Nat. Prod. Indian J. 2007, 3, 151–158. [Google Scholar]
- Villasante, J.; Pérez-Carrillo, E.; Heredia-Olea, E.; Metón, I.; Almajano, M.P. In Vitro Antioxidant Activity Optimization of Nut Shell (Carya illinoinensis) by Extrusion Using Response Surface Methods. Biomolecules 2019, 9, 883. [Google Scholar] [CrossRef]
- Balavandy, S.K.; Shameli, K.; Biak, D.R.B.A.; Abidin, Z.Z. Stirring time effect of silver nanoparticles prepared in glutathione mediated by green method. Chem Cent J. 2014, 8, 11. [Google Scholar] [CrossRef] [Green Version]
- Vijayaraghavan, K.; Ashokkumar, T. Plant-mediated biosynthesis of metallic nanoparticles: A review of literature, factors affecting synthesis, characterization techniques and applications. J. Environ. Chem. Eng. 2017, 5, 4866–4883. [Google Scholar] [CrossRef]
- Hongyu, L.; Huan, Z.; Jie, W.; Wei, J. Effect of temperature on the size of biosynthesized silver nanoparticle: Deep insight into microscopic kinetics analysis. Arab. J. Chem. 2020, 13, 1011–1019. [Google Scholar]
- Ying, S.; Guan, Z.; Ofoegbu, P.; Clubb, P.; Rico, C.; He, F.; Hong, J. Green synthesis of nanoparticles: Current developments and limitations. Environ. Technol. Innov. 2022, 16, 102336. [Google Scholar] [CrossRef]
- Zhang, D.; Ma, X.L.; Gu, Y.; Huang, H.; Zhang, G.W. Green Synthesis of Metallic Nanoparticles and Their Potential Applications to Treat Cancer. Front. Chem. 2020, 8, 799. [Google Scholar] [CrossRef]
- Flores-Córdova, M.A.; Sánchez Chávez, E.; Chávez-Mendoza, C.; García-Hernández, J.L.; Preciado-Rangel, P. Bioactive compounds and phytonutrients in edible part and nutshell of pecan (Carya illinoinensis). Cogent. Food Agric. 2016, 2, 1262936. [Google Scholar]
- Pinheiro do Prado, A.C.; Manion, B.; Seetharaman, K.; Deschamps, F.C.; Barrera, D.; Block, J. Relationship between antioxidant properties and chemical composition of the oil and the shell of pecan nuts [Carya illinoinensis (Wangenh) C. Koch]. Ind. Crops Prod. 2013, 45, 64–73. [Google Scholar] [CrossRef]
- Woo, K.S.; Kim, H.Y.; Hwang, I.G.; Lee, S.H.; Jeong, H.S. Characteristics of the Thermal Degradation of Glucose and Maltose Solutions. Prev. Nutr. Food Sci. 2015, 20, 102–109. [Google Scholar] [CrossRef]
- Chen, X.; Yu, J.; Cui, H.; Xia, S.; Zhang, X.; Yang, B. Effect of Temperature on Flavor Compounds and Sensory Characteristics of Maillard Reaction Products Derived from Mushroom Hydrolysate. Molecules 2018, 23, 247. [Google Scholar] [CrossRef]
- Villarreal-Lozoya, J.E.; Lombardini, L.; Cisneros-Zevallos, L. Phytochemicalconstituents and antioxidant capacity of different pecan [Carya illinoinensis (Wangenh.) K. Koch] cultivars. Food Chem. 2007, 102, 1241–1249. [Google Scholar] [CrossRef]
- De la Rosa, A.L.; Parrilla, A.E.; Shahidi, F. Phenolic compounds and antioxidant activity of krnels and Shells of Mexican pecan (Carya illinoinensis). J. Agric. Food Chem. 2015, 59, 152–162. [Google Scholar] [CrossRef]
- Tonon, R.V.; Brabet, C.; Hubinger, M.D. Anthocyanin stability and antioxidant activity of spray-dried açai (Euterpe oleracea Mart.) juice produced with different carrier agents. Int. Food Res. J. 2010, 43, 907–914. [Google Scholar] [CrossRef]
- Vijayakumar, M.; Priya, K.; Nancy, F.T.; Noorlidah, A.; Ahmed, A.B. Biosynthesis, characterization and anti-bacterial effect of plant-mediated silver nanoparticles using Artemisia nilagirica. Ind. Crops Prod. 2013, 41, 235–240. [Google Scholar] [CrossRef]
- Kaviya, S.; Santhanalakshmi, J.; Viswanathan, B.; Muthumary, J.; Srinivasan, K. Biosynthesis of silver nanoparticles using citrus sinensis peel extract and its antibacterial activity. Spectrochim Acta A. Mol. Biomol. Spectrosc. 2011, 79, 594–598. [Google Scholar] [CrossRef] [PubMed]
- Bharti, S.; Mukherji, S.; Mukherji, S. Extracellular synthesis of silver nanoparticles by Thiosphaera pantotropha and evaluation of their antibacterial and cytotoxic effects. Biotech 2020, 10, 237. [Google Scholar] [CrossRef] [PubMed]
- Pourmortazavi, S.M.; Taghdiri, M.; Makari, V.; Rahimi-Nasrabadi, M. Procedure optimization for green synthesis of silver nanoparticles by aqueous extract of Eucalyptus oleosa. Spectrochim. Acta A Mol. Biomol. Spectrosc. 2015, 5, 1249–1254. [Google Scholar] [CrossRef] [PubMed]
- Guzmán, M.; Dille, J.; Godet, S. Synthesis of silver nanoparticles by chemical reduction method and their antibacterial activity. World Acad. Eng. 2008, 19, 357–364. [Google Scholar]
- Kumar, C.G.; Mamidyala, S.K. Extracellular synthesis of silver nanoparticles using culture supernatant of Pseudomonas aeruginosa. Colloid Surf. B. 2011, 84, 462–466. [Google Scholar] [CrossRef]
- Sonam, C.; Sanjay, G. Green synthesis of AgNPs using Cannabis sativa leaf extract: Characterization, antibacterial, anti-yeast and α-amylase inhibitory activity. Mater. Sci. Energy Technol. 2020, 3, 536–544. [Google Scholar]
- Zia, F.; Ghafoor, N.; Iqbal, M. Green synthesis and characterization of silver nanoparticles using Cydonia oblong seed extract. Appl. Nanosci. 2016, 6, 1023–1029. [Google Scholar] [CrossRef]
- Rahim, K.A.; Mahmoud, S.Y.; Ali, A.M.; Almaary, K.S.; Mustafa, M.A.; Husseiny, S.M. Extracellular biosynthesis of silver nanoparticles using Rhizopus stolonifera. Saudi J. Biol. Sci. 2017, 24, 208–216. [Google Scholar]
- McGinty, J.; Yazdanpanah, N.; Price, C.; Joop, H.; Sefcik, J. CHAPTER 1: Nucleation and Crystal Growth in Continuous Crystallization. In The Handbook of Continuous Crystallization; Royal Society of Chemistry: London, UK, 2020; pp. 1–50. [Google Scholar]
- Darroudi, M.; Ahmad, M.B.; Zamiri, R.; Zak, A.K.; Abdullah, A.H.; Ibrahim, N.A. Time-dependent effect in green synthesis of silver nanoparticles. Int. J. Nanomed. 2011, 6, 677–681. [Google Scholar] [CrossRef]
- Chen, D.; Qiao, X.; Qiu, X. Synthesis and electrical properties of uniform silver nanoparticles for electronic applications. J. Mater Sci. 2009, 44, 1076–1081. [Google Scholar] [CrossRef]
- Kim, J.S.; Kuk, E.; Yu, K.N.; Kim, J.H.; Park, S.J.; Lee, H.J.; Cho, M.H. Antimicrobial effects of silver nanoparticles. Nanomed. Nanotechnol. Biol. Med. 2007, 3, 95–101. [Google Scholar] [CrossRef] [PubMed]
- Csakvari, A.C.; Moisa, C.; Radu, D.G.; Olariu, L.M.; Lupitu, A.I.; Panda, A.O.; Pop, G.; Chambre, D.; Socoliuc, V.; Copolovici, L.; et al. Green Synthesis, Characterization, and Antibacterial Properties of Silver Nanoparticles Obtained by Using Diverse Varieties of Cannabis sativa Leaf Extracts. Molecules 2021, 26, 4041. [Google Scholar] [CrossRef]
- Emami Karvani, Z.; Chehrazi, P. Antibacterial activity of ZnO nanoparticle on gram positive and gram-negative bacteria. Afr. J. Microbiol. Res. 2011, 5, 1368–1373. [Google Scholar]
- Abbaszadegan, A.; Ghahramani, Y.; Gholami, A.; Hemmateenejad, B.; Dorostkar, S.; Nabavizadeh, M.; Sharghi, H. The effect of charge at the surface of silver nanoparticles on antimicrobial activity against gram-positive and gram-negative bacteria: A preliminary study. J. Nanomater. 2015, 2015, 720654. [Google Scholar] [CrossRef] [Green Version]
- Leyva, G.G. Nanopartículas de plata: Tecnología para su obtención, caracterización y actividad biológica. Investig. Discapac. 2013, 2, 18–22. [Google Scholar]
- Savithramma, N.; Linga Rao, M.; Rukmini, K.; Suvarnalatha, P. Antimicrobial activity of Silver Nanoparticles synthesized by using Medicinal Plants. Int. J. Chemtech Res. 2011, 3, 1394–1402. [Google Scholar]
- Ujjyani, G.; Khondakar, S.A.; Snehasis, M.; Bhaumik, D. The Emerging Roles of Silver Nanoparticles to Target Viral Life Cycle and Detect Viral Pathogens. Asian J. Chem. 2022, 17, e202101149. [Google Scholar]
- DuBois, M.; Gilles, K.A.; Hamilton, J.K.; Rebers, P.A.; Smith, F. Colorimetric Method for Determination of Sugars and Related Substances. Anal. Chem. 1956, 28, 350–356. [Google Scholar] [CrossRef]
- López-Contreras, J.J.; Zavala-García, F.; Urías-Orona, V.; Martínez-Ávila, G.C.G.; Rojas, R.; Niño-Medina, G. Chromatic, Phenolic and Antioxidant Properties of Sorghum bicolor Genotypes. Not. Bot. Horti Agrobot. 2015, 43, 366–370. [Google Scholar] [CrossRef] [Green Version]

| Sample | Proteins (%) | Carbohydrates (mg/g of Shell) | ABTS | DPPH | FRAP |
|---|---|---|---|---|---|
| Antioxidant Capacity (µmol TE/100 g) | |||||
| E1 (4 h) | 0.177 a | 352.2 a | 1262.6 b | 154.9 b | 322.4 b |
| E2 (8 h) | 0.159 a | 337.6 a | 1095.6 a | 99.7 a | 107.4 a |
| E3 (12 h) | 0.177 a | 334.2 a | 986.6 a | 116.5 a | 158.1 a |
| Reaction Time | AgNO3 Concentration | ||
|---|---|---|---|
| 1 mM | 2 mM | 4 mM | |
| Size (nm) | |||
| 4 | 98.3 ± 5.3 | 78.6 ± 3.7 | 50.9 ± 3.8 |
| 8 | 93 ± 3.5 | 44.2 ± 1.7 | 50 ± 2.6 |
| 12 | 78 ± 1.7 | 41.6 ± 6.2 | 39.9 ± 3.1 |
| Reaction Conditions | Inhibition Zone (mm) | ||
|---|---|---|---|
| Microorganism | |||
| S. aureus | S. typhi | P. mirabilis | |
| 1 mM/4 h | WI * | 3.17 ± 0.76 b | 1.67 ± 0.57 a |
| 1 mM/8 h | WI * | 2.83 ± 0.28 a | 1.67 ± 0.57 a |
| 1 mM/12 h | WI * | 2.83 ± 0.28 a | 1.33 ± 0.20 a |
| 2 mM/4 h | WI * | 3.67 ± 0.57 b | 3.00 ± 0.20 b |
| 2 mM/8 h | WI * | 3.67 ± 0.57 b | 3.00 ± 0 b |
| 2 mM/12 h | WI * | 5.67 ± 1.52 c | 3.33 ± 0.57 b |
| 4 mM/4 h | 0.67 ± 0.57 a | 5.33 ± 1.52 c | 3.33 ± 0.57 b |
| 4 mM/8 h | 1.00 ± 0 a | 4.67 ± 0.57 c | 4.00 ± 0 b |
| 4 mM/12 h | 1.00 ± 0 a | 4.67 ± 0.57 c | 3.67 ± 0.57 b |
Publisher’s Note: MDPI stays neutral with regard to jurisdictional claims in published maps and institutional affiliations. |
© 2022 by the authors. Licensee MDPI, Basel, Switzerland. This article is an open access article distributed under the terms and conditions of the Creative Commons Attribution (CC BY) license (https://creativecommons.org/licenses/by/4.0/).
Share and Cite
Neira-Vielma, A.A.; Meléndez-Ortiz, H.I.; García-López, J.I.; Sanchez-Valdes, S.; Cruz-Hernández, M.A.; Rodríguez-González, J.G.; Ramírez-Barrón, S.N. Green Synthesis of Silver Nanoparticles Using Pecan Nut (Carya illinoinensis) Shell Extracts and Evaluation of Their Antimicrobial Activity. Antibiotics 2022, 11, 1150. https://doi.org/10.3390/antibiotics11091150
Neira-Vielma AA, Meléndez-Ortiz HI, García-López JI, Sanchez-Valdes S, Cruz-Hernández MA, Rodríguez-González JG, Ramírez-Barrón SN. Green Synthesis of Silver Nanoparticles Using Pecan Nut (Carya illinoinensis) Shell Extracts and Evaluation of Their Antimicrobial Activity. Antibiotics. 2022; 11(9):1150. https://doi.org/10.3390/antibiotics11091150
Chicago/Turabian StyleNeira-Vielma, Alberto Antonio, Héctor Iván Meléndez-Ortiz, Josué Israel García-López, Saúl Sanchez-Valdes, Mario Alberto Cruz-Hernández, Josefina Guadalupe Rodríguez-González, and Sonia Noemí Ramírez-Barrón. 2022. "Green Synthesis of Silver Nanoparticles Using Pecan Nut (Carya illinoinensis) Shell Extracts and Evaluation of Their Antimicrobial Activity" Antibiotics 11, no. 9: 1150. https://doi.org/10.3390/antibiotics11091150
APA StyleNeira-Vielma, A. A., Meléndez-Ortiz, H. I., García-López, J. I., Sanchez-Valdes, S., Cruz-Hernández, M. A., Rodríguez-González, J. G., & Ramírez-Barrón, S. N. (2022). Green Synthesis of Silver Nanoparticles Using Pecan Nut (Carya illinoinensis) Shell Extracts and Evaluation of Their Antimicrobial Activity. Antibiotics, 11(9), 1150. https://doi.org/10.3390/antibiotics11091150

